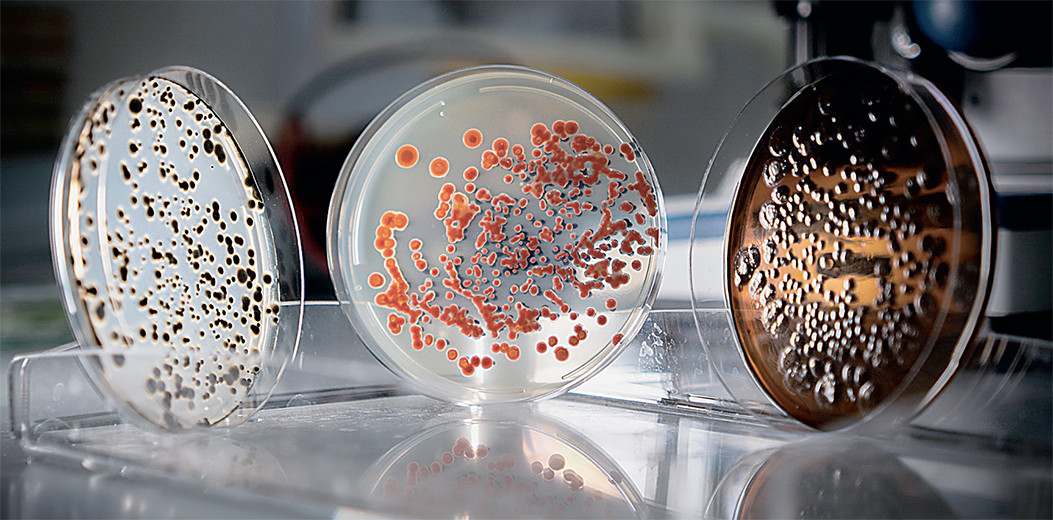

Вести из лабораторий и институтов
Микробный консорциум для жизни на Марсе
Человечество не оставляет идею марсианских садов и шаг за шагом движется к этой цели. Одним из таких шагов стал совместный эксперимент Академии биологии и медицины им. Д. И. Ивановского Южного федерального университета (ЮФУ) и Института медико-биологических проблем (ИМБП) РАН. Исследователи разработали консорциум из десяти штаммов микроорганизмов и отправили их на околоземную орбиту на борту космического аппарата «Бион-М» № 2. Цель эксперимента — изучить, как сложное сообщество бактерий и грибов переносит экстремальные условия космического полёта: повышенную радиацию, невесомость и перегрузки. Уровень радиационного воздействия на орбите высотой 370—380 км, на которую был выведен «Бион-М» № 2, более чем в 200 раз превышает земной фон и на 30% выше, чем на МКС.
Микробный консорциум представляет собой специально подобранное, совместно культивируемое сообщество микроорганизмов (бактерий, дрожжей), которые вступают в сложные симбиотические взаимосвязи и тем самым помогают друг другу расти и выживать. В состав отправленного в космос образца вошли новые штаммы почвенных бактерий и грибов, отобранные из природных почв Ростовской области и почв с техногенным загрязнением. Каждый участник этого микробного коллектива выполняет свою функцию: цианобактерии отвечают за фотосинтез, актиномицеты и бациллы — за наработку биомассы. Некоторые из микроорганизмов продуцируют вещества, способные увеличить плодородие почв, другие обеспечивают устойчивость к окислительному стрессу.
Биологические образцы находились на околоземной орбите практически два месяца: они были отправлены в космос 20 августа и доставлены на Землю 18 октября 2025 года. Их изучение после приземления подтвердило, что все микроорганизмы в составе консорциума успешно пережили полёт, хотя некоторые из них немного замедлили рост, а красные дрожжи Rhodothorula мутировали — у них оказалось повышенное число белых непигментированных клеток. Теперь предстоит детально изучить, как космический полёт повлиял на частоту мутаций в ДНК микроорганизмов.
Созданный консорциум микроорганизмов имеет специальное назначение — восстановление свойств загрязнённых человеком территорий или плодородного слоя почвы после пожаров и освоение безжизненных субстратов, таких как почвы пустынь, Крайнего Севера, а также других планет. Космический эксперимент показал, что консорциум вполне устойчив к экстремальным условиям. Но поможет ли подобное сообщество микроорганизмов превратить мёртвый марсианский грунт в почву, дающую жизнь?
В ЮФУ параллельно с экспериментом на околоземной орбите вели исследования в лаборатории: сообщество микроорганизмов, аналогичное побывавшему на околоземной орбите, культивировали в прототипе марсианского реголита — грунте из пустыни Мохаве (расположена на юго-западе Соединённых Штатов Америки). Этот грунт хорошо имитирует свойства красного песка, покрывающего поверхность Марса. И в ноябре 2025 года в этой «марсианской» почве, обработанной аналогичным консорциумом, взошли первые ростки ячменя.
Результаты исследования позволят не только оценить пределы живучести земных микроорганизмов, но и приблизят человечество к созданию устойчивых замкнутых экосистем для жизни вне Земли.
